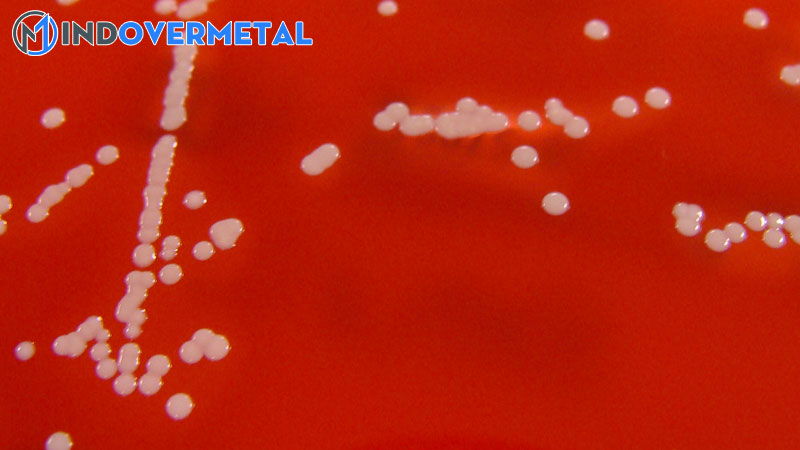
dac-diem-cua-staphylococcus-haemolyticus-phan-loai-hinh-thai-sinh-benh-hoc-2-mindovermetal

Staphylococcus haemolyticus Nó là một loại vi khuẩn hình cầu dừa dương tính. Nó là một phần của hệ vi sinh vật bình thường của da ở người, động vật linh trưởng và động vật nuôi. Nó đi vào phân loại của Staphylococcus coagulase âm tính và cho đến gần đây, nó không được đề cập nhiều. Cùng mindovermetal tìm hiểu chi tiết hơn trong bài viết dưới đây!
Tuy nhiên, loài này đã trở nên quan trọng, chính bới nó đã được phân lập từ nhiều mẫu lâm sàng. Trong thời hạn gần đây, năng lực tuyệt vời của nó để có được năng lực kháng kháng sinh thường được sử dụng trong bệnh viện đã được nghiên cứu và điều tra .
Điều này đã làm tăng số lượng những bệnh nhiễm trùng bệnh viện và cùng với đó là tỷ suất mắc bệnh và tỷ suất tử trận do Staphylococcus âm tính coagulase. Ở 1 số ít TT y tế, những chủng đặc hữu đã được phân lập gây nhiễm khuẩn huyết ở những đơn vị chức năng chăm nom đặc biệt quan trọng

Những nhiễm trùng này hoàn toàn có thể là do sự nhiễm bẩn của những vật tư giả như van tim, ghép mạch máu, máy tạo nhịp tim, cấy ghép bơm nội sọ, mắt lưới, vú, khớp hoặc dương vật giả ..Cũng bởi sự ô nhiễm của những thiết bị y tế như ống thông tĩnh mạch, shunt CSF, ống thông thẩm phân phúc mạc, ống thông đường tiểu, vật tư khâu, trong số những người khác
Nó ảnh hưởng tác động đến bệnh nhân bị ức chế miễn dịch, đặc biệt quan trọng là bệnh nhân bạch cầu trung tính và trẻ sơ sinh. Tuy nhiên, nhiễm trùng do Staphylococcus haemolyticus chúng hoàn toàn có thể có nguồn gốc bệnh viện hoặc có nguồn gốc hội đồng. Đó là, nó khả thi trong cả hai môi trường tự nhiên
Mục lục nội dung
Đặc điểm chung
– Staphylococcus haemolyticus là một vi sinh vật kỵ khí tùy tiện, không di động và không hình thành bào tử
– Nó tăng trưởng tốt trong môi trường tự nhiên nuôi cấy được làm giàu bằng máu từ 18 ° C – 45 ° C. Với nhiệt độ tối ưu là 37 ° C .
– Nó được đặc trưng bằng cách cho một phản ứng âm tính với xét nghiệm coagulase, urê, decarboxyl hóa ornithine và phosphatase
– Phản ứng tích cực với : thử nghiệm catalase, nitrit, arginine, pyrrolidone-larilamidase ( PYR ).
– Liên quan đến sự hình thành axit từ carbohydrate được phân biệt bằng cách axit hóa glucose, maltose, trehalose và sucrose
– Nó hoàn toàn có thể cho hiệu quả khác nhau trước khi cho đường sữa, fructose, ribose và mannitol, và không lên men mannose, raffinose, cellobiose, arabinose và xyloza
– So với những thuốc chống vi trùng được sử dụng cho mục tiêu chẩn đoán, polymyxin B và novobiocin, hoạt động giải trí như nhạy cảm và chống lại bacitracin là kháng .
Hình thái
Chúng là những quả dừa nhuộm màu tím dưới vết Gram, nghĩa là chúng dương thế với Gram .Sự phân bổ của nó trong khoảng trống giống như của bất kể chủng staphylococcus nào, nghĩa là trong những cụm mô phỏng những chùm nho.

Chúng có size từ 0,8 đến 1,3 mm đường kính .Về mặt vĩ mô, những khuẩn lạc trên thiên nhiên và môi trường thạch máu có màu trắng kem và tạo ra ß-tán huyết xung quanh thuộc địa. Xem hình ảnh bên trái trong phần trình làng của bài viết .Staphylococcus haemolyticus trình diễn axit teichoic trong thành tế bào của nó và hoàn toàn có thể tạo ra một viên nang polysacarit .
Phân loại
Tên miền: Vi khuẩn .Phylum : Firmicutes .Lớp : Bacilli .Đặt hàng : Bacillales .Họ : Staphylococcaceae .Chi Staphylococcus .Loài : tan máu .
Yếu tố độc lực
Phát hiện gen mecA
Một trong những yếu tố chính S. haemolyticus là năng lực có được những gen kháng kháng khuẩn, làm phức tạp những hình ảnh lâm sàng .Tương tự như vậy, loài này đóng một vai trò quan trọng trong việc thông dụng những gen kháng thuốc, góp thêm phần vào sự Open của những dòng vô tính dịch bệnh khác nhau ..
Vi sinh vật này đã báo cáo kháng cao với methicillin.
Được biết, chính sách kháng methicillin trong Staphylococcus quyết định hành động năng lực kháng toàn bộ những loại kháng sinh b-lactam : penicillin, cephalosporin, carbapenems và monobactams .Sự đề kháng này được trung gian bởi sự sản xuất quá mức của PBP-2a, biến hóa protein gắn penicillin với ái lực thấp với kháng sinh-Lactam và được mã hóa bởi gen mecA .
Kháng các thuốc chống vi trùng khác
Tương tự như vậy, nó đã thấy kháng thuốc cao so với những nhóm kháng sinh khác như ciprofloxacin, erythromycin và gentamicin. Trong khi, nó phân phối rất tốt với linezolid và rifampicin, sau đó là trimethoprim-sulfamethoxazole và vancomycin
Đối với vancomycin, những trường hợp kháng thuốc không như nhau đáng kể đã được báo cáo giải trình. Điều này đã cản trở điều trị thành công xuất sắc ở bệnh nhân sơ sinh, giảm bạch cầu và chăm nom đặc biệt quan trọng
Kháng với glycopeptide là tác dụng của việc thu nhận và biểu lộ những operon sửa chữa thay thế đầu nối D-lactate hoặc D-serine cho D-alanine, làm giảm ái lực kết nối với vancomycin .Staphylococcus haemolyticus đặc biệt quan trọng có xu thế kháng với glycopeptide, do tính dẻo của bộ gen đặc biệt quan trọng và khuynh hướng kiểm soát và điều chỉnh DNA tiếp tục.
Viên nang polysacarit
Nó chống lại sự kháng thực bào
Sản xuất màng sinh học
Nó đã được nhìn thấy rằng S. haemolyticus Nó có năng lực hình thành màng sinh học trong ống thông tĩnh mạch và chân giả. Đặc tính này làm tăng sức đề kháng với kháng sinh bằng cách hoạt động giải trí như một hàng rào không thấm nước, lê dài và làm phức tạp những quy trình truyền nhiễm .Tính chất này được tăng lên trong những chủng có số lượng giới hạn và với sự hiện hữu của glucose và NaCl trong thiên nhiên và môi trường .

Hemolysin và Enterotoxin
100 % những chủng sản xuất hemolysin, rõ ràng với quầng sáng rõ ràng xung quanh những khuẩn lạc trên thiên nhiên và môi trường thạch máu cừu, trong khi chỉ 1 số ít hoàn toàn có thể tạo ra enterotoxin
Lipase và lecithinase
Một số chủng được sản xuất bởi những người khác .
Bệnh lý
Trong số những bệnh lý đó Staphylococcus haemolitycus nguồn gốc là : Vi khuẩn máu, nhiễm trùng vết thương, bàn chân đái tháo đường, viêm tủy xương, nhiễm trùng nhãn khoa sau phẫu thuật, viêm nội tâm mạc, viêm màng não
Dịch tễ học
Trong một điều tra và nghiên cứu được triển khai tại Bệnh viện II của Chocope Peru, những chủng Stpahylococcus haemolitycus từ nhiều nguồn khác nhau có được tỷ suất Tỷ Lệ phục sinh như sau :Dịch âm đạo 25 %, tinh trùng 25 %, bài tiết đốt sống 20,8 %, bài tiết hầu họng 16,7 %, nước tiểu 8,3 %, vết thương 4,2 %
Các nhà nghiên cứu khác đã triển khai một nghiên cứu và điều tra tựa như ở Paraguay và thu được: trong nước tiểu 27,3 %, dịch tiết ra ( áp xe và vết thương ) 18,5 %, cấy máu, đầu ống thông và xương 13,3 % .Tương tự như vậy, một nghiên cứu và điều tra khác cho thấy 55,9 % trẻ sơ sinh trong môi trường tự nhiên bệnh viện có Staphylococcus coagulase âm tính đa kháng thuốc trong khoang mũi
Các loài tiếp tục bị cô lập nhất là S. haemolyticus ( 38,3 % ) và S. cholermidis ( 38,0 % ). Mặt khác, những chủng đa kháng S. haemolyticus chúng cũng gây ra một yếu tố nghiêm trọng trong bệnh lý động vật hoang dã, vì chúng đã được phân lập từ cả động vật hoang dã nhai lại và động vật nuôi
Do đó, có một năng lực lớn là lây truyền giữa động vật hoang dã, chủ sở hữu và bác sĩ thú y. Động vật hoàn toàn có thể đóng vai trò là ổ chứa những chủng S. haemolyticus đa kháng. Ngoài ra, S. haemolitycus hoàn toàn có thể là nơi chứa những gen kháng những loại staphylococci khác, gồm có S. aureus
Chẩn đoán
Staphylococcus coagulase chủng âm tính gồm có Staphylococcus haemolyticus hoàn toàn có thể được xác lập bằng mạng lưới hệ thống bán tự động hóa MicroSscan ® hoặc ALPI-Staph (Biomerieux ©) để đề cập đến 1 số ít. Hệ thống này được cho phép xác lập những loài Staphylococcus bằng cách:
- Phát hiện sự phát triển của vi khuẩn bằng độ đục.
- Phát hiện thay đổi pH.
- Sử dụng chất nền.
- Tăng trưởng so với các chất chống vi trùng nhất định.
Tất cả điều này sau 16-48 giờ ủ ở 37 ° C .
Điều trị
Trong nhiễm trùng ống thông tĩnh mạch nên xem xét năng lực vô hiệu nó, nếu điều này là không hề thì nó phải được niêm phong .

Đồng thời, điều trị bằng kháng sinh nên được dùng với vacomycin, linezolid hoặc daptomycin. Việc sử dụng cloxacillin bị hạn chế ở các chủng nhạy cảm với methicillin.
Trong trường hợp nhiễm trùng chân tay giả, nên điều trị lê dài, phối hợp rifampin và fluoroquinolone hoặc linezolid .Điều trị này hầu hết luôn luôn tránh được sự thiết yếu phải vô hiệu chân giả. Tuy nhiên, nếu nhiễm trùng không giảm, nó phải được vô hiệu .Trong viêm màng não và endophthalmitis sau phẫu thuật hoàn toàn có thể được điều trị bằng linezolid
